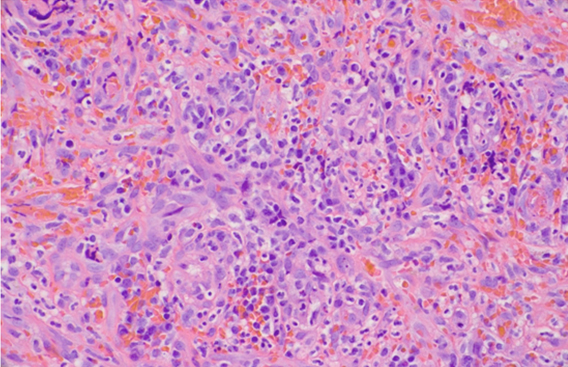

|
Case Report
Acquired immunodeficiency syndrome related Kaposi sarcoma of the rectum in the absence of cutaneous manifestation
1 Department of Internal Medicine, The University of Texas at Austin Dell Medical School, Austin, Texas, United States
2 Department of Diagnostic Medicine, The University of Texas at Austin Dell Medical School, Austin, Texas, United States
3 Department of Internal Medicine, Division of Gastroenterology and Hepatology, The University of Texas at Austin Dell Medical School, Austin, Texas, United States
Address correspondence to:
Paul Guzik
1500 Red River St., Austin, Texas 78701,
United States
Message to Corresponding Author
Article ID: 101181Z01PG2020
Access full text article on other devices

Access PDF of article on other devices

How to cite this article
Guzik P, Kim C, Rivera-Begeman A, Tang D. Acquired immunodeficiency syndrome related Kaposi sarcoma of the rectum in the absence of cutaneous manifestation. Int J Case Rep Images 2020;11:101181Z01PG2020.ABSTRACT
Introduction: In developed countries, the incidence of Kaposi sarcoma (KS) has declined substantially with more widespread use of antiretroviral therapy (ART). The initial presentation of KS is usually cutaneous lesions. Uncommonly, KS is discovered in visceral organs without skin involvement. Isolated KS of the rectum is rare.
Case Report: A 41-year-old man with history of iron deficiency anemia and external hemorrhoids presented with worsening rectal bleeding over three years with associated tenesmus and weight loss. On exam, no skin lesions were identified. Hemoglobin was 5.4 g/dL. Rapid human immunodeficiency virus (HIV) screen was positive. Absolute CD4 count was 37/uL. HIV-1 viral load was 328,790 copies/mL. Computed tomography (CT) scan revealed an irregular, circumferential 7 cm rectal mass with associated rectal and pelvic lymphadenopathy. Colonoscopy revealed a non-obstructing, circumferential, friable, ulcerated, nodular mass from the dentate line to 14 cm. Biopsy revealed ulcerated tissue and spindle cell proliferation with HHV-8 positive endothelial cells.
Conclusion: We describe the case of a 41-year-old man with newly diagnosed HIV/AIDS and latent syphilis who presented with rectal bleeding and was found to have KS of the rectum with no prior history of skin lesion nor any evidence of cutaneous disease seen on thorough physical examination. Although uncommon, KS can present on visceral surfaces, such as the gastrointestinal (GI) tract, in the absence of cutaneous lesions. Isolated anorectal KS in the absence of skin involvement is rarely seen. Despite an endoscopic appearance which mimics adenocarcinoma, rectal KS should remain in the differential for rectal mass in an immunosuppressed patient, even without typical cutaneous lesions.
Keywords: Colonoscopy, HIV/AIDS, Kaposi sarcoma, Rectal mass
Introduction
Kaposi sarcoma (KS) is an angioproliferative neoplasm and one of the most common human immunodeficiency virus/acquired immunodeficiency syndrome (HIV/AIDS) related malignancies [1],[2],[3]. In developed countries, the incidence of KS has declined substantially due to the more widespread use of antiretroviral therapy (ART) [2],[3]. Kaposi sarcoma often manifests as a cutaneous disease but can disseminate to other visceral organs if left untreated. The upper GI tract is the most common extracutaneous site for disseminated KS [3]. In one case series, skin lesions were found in 80% of patients with gastric involvement [1],[4]. Less commonly, KS is found in the lower GI tract. Rarely, lower GI-KS is discovered in the absence of cutaneous disease [2],[4]. The following case describes a 41-year-old homosexual male with newly diagnosed HIV/AIDS and latent syphilis found to have rectal KS in the absence of any cutaneous involvement.
Case Report
A 41-year-old man with a past medical history of iron deficiency anemia and external hemorrhoids presented with rectal pain during defecation and associated rectal bleeding for nearly three years prior to admission. The rectal bleeding was initially intermittent and bright red in color, though in the six months prior to admission the bleeding occurred daily. The bleeding was refractory to topical treatment for hemorrhoids. In the three weeks prior to admission, the patient endorsed increased bleeding with passage of blood clots. The patient also noted weight loss of 15 lbs and night sweats. He denied a personal history of skin rashes or lesions. His sexual history was notable for unprotected intercourse with men. He denied any family history of colorectal cancer. The patient denied intravenous drug use.
The patient’s initial vital signs revealed a blood pressure of 129/79 mmHg, a heart rate 102 bpm, and a temperature 99.5 °F. On rectal exam, two tender non-thrombosed external hemorrhoids were noted with no signs of active bleeding. No skin rashes or lesions were identified. Labs were notable for a hemoglobin of 5.4 g/dL and after transfusion of two units of packed red blood cells, his hemoglobin improved to 8.5 g/dL. Carcinoembryonic antigen was 0.9 ng/mL. Rapid HIV screen was positive. An absolute CD4 count was 37/uL. An HIV-1 viral load was 328,790 copies/mL. Rapid plasma reagin was reactive with 1:1 titer. Computed tomography of the abdomen and pelvis with intravenous contrast revealed an irregular, asymmetric, circumferential rectal mass that measured 7 cm in length with associated increased density in the medial rectal fat as well as rectal and pelvic lymphadenopathy up to 8 mm in size.
Colonoscopy revealed a normal cecum, ascending, transverse, descending, and sigmoid colon. A non-obstructing, circumferential, friable, ulcerated, nodular mass was seen from the dentate line to 14 cm (Figure 1). Multiple forceps biopsies were taken and the proximal margin of the mass was tattooed. Biopsy histology revealed ulcerated tissue with a granulation tissue like appearance, though a proliferation of bland spindle cells without increased mitotic activity was also seen (Figure 2). Human herpesvirus 8 (HHV-8) positive endothelial cells were noted within these spindle cells (Figure 3) and overall morphology was diagnostic of KS. Background rare spirochetes were identified, consistent with the patient’s known Treponema pallidum (syphilis) infection. Of note, within the mixed inflammatory infiltrate were some larger lymphocytes and increased atypical-appearing plasma cells along with scattered Epstein–Barr virus (EBV) positive cells. However, given the absence of a distinct clonal population by flow cytometry or immunohistochemistry, these latter findings were felt to be more in keeping with a reactive process rather than an EBV-driven lymphoproliferative disorder. The specimen was negative for granulomata or carcinoma.
The patient was started on therapy for latent syphilis with penicillin G injections. Pneumocystis carinii pneumonia (PCP) and Mycobacterium avium (MAC) prophylaxis were started. No further bleeding events were noted during admission and the hemoglobin remained between 8 and 9 g/dL. Oral iron therapy was continued at discharge. The patient was initiated on ART.
Discussion
Kaposi sarcoma develops by an unknown mechanism after infection with HHV-8 and has a well-known association with immunodeficiency states such as AIDS. In the era of ART, the incidence and severity of AID-Srelated KS has declined precipitously. AIDS-related KS is the most common and aggressive form of KS in the United States [2].
The initial presentation of KS is usually cutaneous lesions described as variable purplish, reddish blue, or dark brown/black macules, plaques, and nodules on the skin that may ulcerate and bleed [5]. Left untreated, cutaneous KS disseminates to other visceral organs in about half of patients [2],[6]. Uncommonly, KS is found on visceral surfaces in the absence of cutaneous lesions. When KS invades the GI tract, 60–90% of cases are found in the upper GI tract [6]. Of the cases with lower GI tract involvement, colonic KS is more frequently observed compared to anorectal KS. Very few cases of isolated anorectal KS have been observed in the literature [4],[7].
Patients with GI involvement of KS (GI-KS) are often asymptomatic but, depending on the location of the disease, may present with weight loss, abdominal pain, nausea, vomiting, diarrhea, upper or lower gastrointestinal bleeding, malabsorption, or intestinal obstruction [6]. Symptomatic patients prompt endoscopic evaluation with biopsy for histological and immunohistochemical (IHC) testing as it can be mistaken for other diseases, such as adenocarcinoma [3]. Early GI-KS lesions tend to involve the submucosa and therefore can be missed with biopsy. Higher grade or more advanced lesions tend to be more invasive and disseminate. The presence of spindle cell proliferation and extensive lymphoplasmacytic cell infiltrates on histology in conjunction with IHC testing revealing HHV-8 latent nuclear antigen expression confirms the diagnosis of KS [8]. Treatment of KS is often reserved for symptomatic patients and is aimed at inhibiting KS cell growth, invasion, and angiogenesis with ART and systemic chemotherapy with liposomal doxorubicin [6]. Relapse of KS is approximately 13% at four years with most relapses occurring in the first year [6].
Conclusion
We describe the case of a 41-year-old man with newly diagnosed HIV/AIDS and latent syphilis who presented with rectal bleeding and was found to have KS of the rectum with no prior history of skin lesion nor any evidence of cutaneous disease seen on thorough physical examination. Despite an endoscopic appearance which mimics adenocarcinoma, rectal KS should remain in the differential for rectal mass in an immunosuppressed patient, even without typical cutaneous lesions.
REFERENCES
1.
Rezende REF, Kahwage RL, da Costa TV, et al. Upper gastrointestinal Kaposi’s sarcoma in HIV-infected patients: Ten years of endoscopy observation at a single Brazilian center. Int J Infect Dis 2015;39:110–5. [CrossRef]
[Pubmed]

2.
Kumar A, Nautsch D. Kaposi’s sarcoma of the rectum in a homosexual male with HIV-AIDS. ACG Case Rep J 2016;3(4):e192. [CrossRef]
[Pubmed]

3.
Medina-Piñón I, Wah-Suárez M, Acosta-Calderón LA, Ramos-Jiménez J. Extensive AIDS-associated Kaposi’s sarcoma. Int J Infect Dis 2018;67:137–8. [CrossRef]
[Pubmed]

4.
5.
Bhutani M, Polizzotto MN, Uldrick TS, Yarchoan R. Kaposi sarcoma-associated herpesvirus-associated malignancies: Epidemiology, pathogenesis, and advances in treatment. Semin Oncol 2015;42(2):223–46. [CrossRef]
[Pubmed]

6.
Le Mouel JP, Chatelain D, Hautefeuille V. Gastrointestinal: Disseminated Kaposi’s sarcoma. J Gastroenterol Hepatol 2018;33(7):1309. [CrossRef]
[Pubmed]

7.
Lorenz HP, Wilson W, Leigh B, Schecter WP. Kaposi’s sarcoma of the rectum in patients with the acquired immunodeficiency syndrome. Am J Surg 1990;160(6):682–3. [CrossRef]
[Pubmed]

8.
Lee AJ, Brenner L, Mourad B, Monteiro C, Vega KJ, Munoz JC. Gastrointestinal Kaposi’s sarcoma: Case report and review of the literature. World J Gastrointest Pharmacol Ther 2015;6(3):89–95.
[Pubmed]

SUPPORTING INFORMATION
Author Contributions
Paul Guzik - Conception of the work, Design of the work, Acquisition of data, Analysis of data, Drafting the work, Revising the work critically for important intellectual content, Final approval of the version to be published, Agree to be accountable for all aspects of the work in ensuring that questions related to the accuracy or integrity of any part of the work are appropriately investigated and resolved.
Christopher Kim - Conception of the work, Design of the work, Acquisition of data, Analysis of data, Drafting the work, Revising the work critically for important intellectual content, Final approval of the version to be published, Agree to be accountable for all aspects of the work in ensuring that questions related to the accuracy or integrity of any part of the work are appropriately investigated and resolved.
Amanda Rivera-Begeman - Conception of the work, Design of the work, Acquisition of data, Analysis of data, Drafting the work, Revising the work critically for important intellectual content, Final approval of the version to be published, Agree to be accountable for all aspects of the work in ensuring that questions related to the accuracy or integrity of any part of the work are appropriately investigated and resolved.
David Tang - Conception of the work, Design of the work, Acquisition of data, Analysis of data, Drafting the work, Revising the work critically for important intellectual content, Final approval of the version to be published, Agree to be accountable for all aspects of the work in ensuring that questions related to the accuracy or integrity of any part of the work are appropriately investigated and resolved.
Guarantor of SubmissionThe corresponding author is the guarantor of submission.
Source of SupportNone
Consent StatementWritten informed consent was obtained from the patient for publication of this article.
Data AvailabilityAll relevant data are within the paper and its Supporting Information files.
Conflict of InterestAuthors declare no conflict of interest.
Copyright© 2020 Paul Guzik et al. This article is distributed under the terms of Creative Commons Attribution License which permits unrestricted use, distribution and reproduction in any medium provided the original author(s) and original publisher are properly credited. Please see the copyright policy on the journal website for more information.